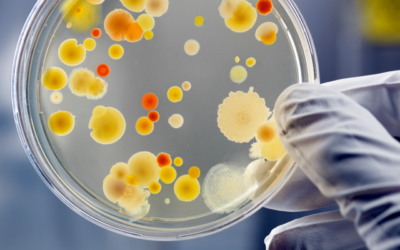
The fight against AMR

News & Blog
How achieving Universal Health Coverage motivates us
Amsterdam, 12 December 2022 – On Universal Health Coverage Day we raise awareness of the importance to leave no one behind. At IDA Foundation, it is our...
Meeting with MOHAP UAE
Last month, our QA Director Bart van Osch and Bincy Mathew, our Pharmacist for IDA MEA, paid a visit to the Ministry of Health and Prevention (MOHAP, United...
Increasing access to HIV/AIDS products
Amsterdam, 1 December 2022 – Today is World AIDS Day, a day where we spread awareness of the status of the HIV/AIDS epidemic and we encourage progress in...
Closing anniversary year with successful event in Mumbai
Last week marked the 50th Anniversary of IDA. Following a successful event with customers and partners in Amsterdam in September, last week, we brought...
Wrapping up a special year
Today, 21 November 2022, marks our official 50th anniversary. With this milestone we look back at 50 years of bridging the gap in access to medicines and...
Shipping emergency health goods to Afghanistan
Amsterdam, 23 November 2022 – Today we would like to give some attention to our customer International Medical Corps (IMC) by discussing a recent...
The fight against AMR
Amsterdam, 18 November 2022 – Today is the kick-off of the annual World Antimicrobial Awareness Week (WAAW). This week aims to create awareness around...
Climate change impacts global health
Amsterdam, 8 November 2022 – From 6-18 November, global leaders are gathering in Sharm El-Sheikh, to discuss climate change; one of the largest issues...
Building local networks with partners
Amsterdam, 2 November 2022 – Strengthened Local Capacity is one of our long-term goals. In our mission of bridging the gap in access to medicines, we foresee...